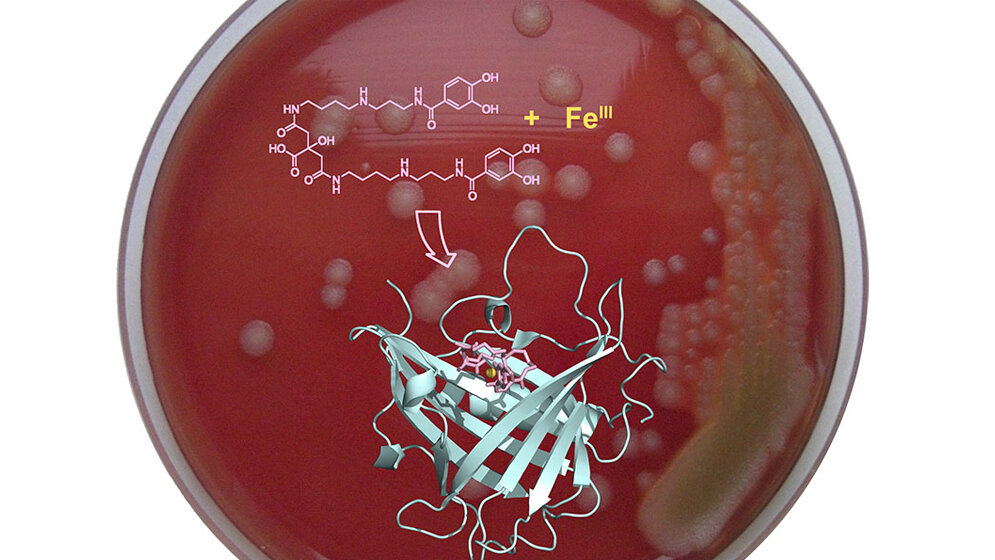
Indem_ein_spezieller_Eisen_Komplexbildner_neutralisiert_wird_kann_der_Anthrax_Bazillus_kein_Eisen_mehr_aufnehmen_Bild_Skerra_TUM.jpg Anthrax

Da sich der Milzbrand-Erreger erst durch den Zugang zum Element Eisen im Körper verbreitet, sollte dies eine effektive Behandlung der lebensbedrohlichen Infektion ermöglichen. Milzbrand, auch Anthrax genannt, wird von Bakterien ausgelöst. Der Milzbrand-Erreger kann zwar mit einem Antibiotikum bekämpft werden, jedoch ist das Gift, welches er im Körper abgibt, besonders gefährlich. Wird die Infektion zu spät erkannt, kann sie oft tödlich enden.
Mensch kann sich anstecken
Der Milzbrand-Erreger überdauert unter Umständen jahrzehntelang im Boden in Form sogenannter Sporen. Grasende Tiere wie etwa Rinder oder Schafe nehmen die Sporen auf und erkranken an Milzbrand. Menschen, die mit diesen Nutztieren oder mit Tierprodukten arbeiten, können sich infizieren. In Deutschland treten heute jedoch nur noch sehr selten Fälle von Anthrax bei Tierherden auf. Aber auch wenn Fleisch erkrankter Tiere nicht ausreichend erhitzt wurde, kann sich der Mensch damit anstecken.
Ende August dieses Jahres etwa traten bei Nutztieren im Südosten Frankreichs Milzbranderkrankungen auf – der heftigste Ausbruch seit 20 Jahren, berichteten französische Medien. Zudem ist der Bestand von wildlebenden Schimpansen und Gorillas durch Milzbrand gefährdet.
Heute stellt Anthrax vor allem als potentielle Biowaffe eine weltweite Bedrohung dar. So wurden im Jahr 2001 in den Vereinigten Staaten von Amerika mehrere Briefe mit Milzbrandsporen verschickt. Damals starben fünf Menschen.
Eisen ohne Transporteur
Bakterien benötigen wie jede Körperzelle das essentielle Spurenelement Eisen. Dieses ist in Körperflüssigkeiten jedoch fest an Proteine gebunden, also nicht einfach verfügbar. Bakterien produzieren daher spezielle Komplexbildner namens Siderophore (Eisenträger), um die wenigen freien Eisen-Ionen zu binden und anschließend über bakterieneigene Transportsysteme aufzunehmen. Dem setzt das menschliche Immunsystem ein im Blut zirkulierendes Protein entgegen, das Siderocalin, welches die Eisen-Siderophore hochaffin aufnimmt und über die Niere ausscheidet.
Das sogenannte Petrobactin ist ein spezieller Eisenträger des Milzbranderregers, welches vom Siderocalin nicht erkannt wird. Die Idee von Prof. Skerra vom Lehrstuhl für Biologische Chemie war, dieses Anthrax-Siderophor außer Gefecht zu setzen und damit die Vermehrung des Milzbrand-Erregers zu bremsen. Mithilfe der an seinem Lehrstuhl entwickelten Anticalin® Technologie konnte sein Team das körpereigene Siderocalin umkonstruieren. Als Resultat entstand das „Petrocalin“, welches den Siderophor des Milzbranderregers neutralisieren kann.
Petrocalin fängt Petrobactin ab
„Das neu entwickelte Petrocalin fängt Petrobactin ab und entzieht damit dem Milzbranderreger den Zugang zum lebensnotwendigen Eisen, was wie ein Protein-Antibiotikum wirkt“, sagt Skerra – „in Kooperation mit Professor Siegfried Scherer vom Lehrstuhl für Mikrobielle Ökologie konnten wir jüngst beweisen, dass dieser Ansatz in Bakterienkulturen funktioniert.“
Skerras Ansatz eröffnet einen neuen Behandlungsweg von Milzbrand-Infektionen, indem die Ausbreitung des Bakteriums im Körper des Patienten effektiv unterdrückt wird. Die biochemischen und proteinstrukturellen Analysen, die Skerra und Kollegen nun veröffentlichen, liefern zudem Einblicke in die molekularen Mechanismen.
Mehr Informationen:
Für die beschriebene Studie wurde mit einem abgeschwächten Laborstamm gearbeitet, nicht jedoch mit dem humanpathogenen Erreger. (idw, red)
Martin Dauner, Andreas Eichinger, Genia Luecking, Siegfried Scherer and Arne Skerra: Reprogramming Human Siderocalin to Neutralize Petrobactin, the Essential Iron Scavenger of Anthrax Bacillus. Angew. Chemie Int. Edition 2018. DOI: 10.1002/anie.201807442.
Artikel teilen